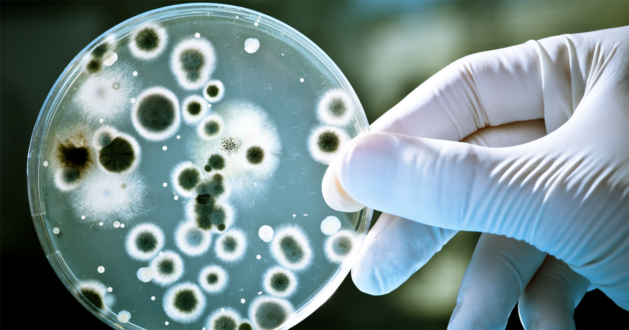

17 Aralık 2022
Aralık 2022’de Lancet’te yayımlanan öncü bir çalışma, 2019’da görülen infeksiyonla ilişkili yaklaşık 13.7 milyon ölümden 7.7 milyonunun 33 bakteriyel patojen ve 11 bulaşıcı hastalıkla ilişkili olduğunu ortaya koydu.
Küresel Hastalık, Yaralanma ve Risk Faktörleri Çalışması (GBD) 2019 verilerine dayanan çalışma, başlıca 11 bulaşıcı hastalıkta 33 bakteriyel patojene bağlı küresel ölüm oranlarına ilişkin kapsamlı tahminler sundu. 2019’da infeksiyonla ilişkili yaklaşık 13.7 milyon ölümden 7.7 milyon tanesi 33 bakteriyel patojen ve 11 bulaşıcı hastalıkla ilişkilendirildi. Otuz üç patojenden kaynaklanan ölümlerin yarısından fazlasından aralarında Staphylococcus aureus ve Escherichia coli’nin de bulunduğu başlıca beş patojen sorumluydu. Bu bakteriyel patojenlerle ilişkili ölümler, 2019’un ikinci önde gelen ölüm nedeni olarak sınıflandırıldı. Aşı gibi önleyici uygulamalara ve optimize edilmiş antibiyotik kullanımına acilen yatırım yapılması gerektiği vurgulandı.